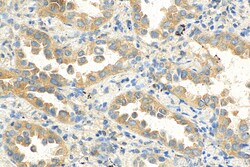
NeutraKine IL-10 Mouse Monoclonal Antibody, Proteintech Unconjugated; 100

missing translation for 'onlineSavingsMsg'
Learn More
Learn More
NeutraKine™ IL-10 Mouse Monoclonal Antibody, Proteintech
Mouse Monoclonal Antibody
Brand: Proteintech 69018-1-IG-100UG
This item is not returnable.
View return policy
Description
The NeutraKine™ IL-10 antibody from Proteintech is a mouse monoclonal antibody generated with recombinantprotein of human NeutraKine™ IL-10. This antibody recognizes human antigen. The NeutraKine™ IL-10 antibody has been validated for the following applications: IHC, ELISA, Neutralization analysis.Specifications
| IL-10 | |
| Monoclonal | |
| Unconjugated | |
| Mouse | |
| Protein G purification | |
| RUO | |
| 3586 | |
| Lyophilized antibodies are stable for 1 year from the date of receipt if stored between (-20°C) and (-80°C). Upon reconstitution we recommend that the solution can be stored at(4°C) for short term or at(-20°C) to (-80°C) for long term. Repeated freeze thaw cycles should be avoided with reconstituted products. | |
| Liquid |
| Immunohistochemistry, ELISA, Neutralization | |
| 1E4F5 | |
| CSIF; IL-10; IL10A; MGC126450; MGC126451; TGIF | |
| RecombinantProtein | |
| 100 μg | |
| Primary | |
| Human | |
| Neu Antibody | |
| IgG1 |
Product Content Correction
Your input is important to us. Please complete this form to provide feedback related to the content on this product.
Product Title
Spot an opportunity for improvement?Share a Content Correction